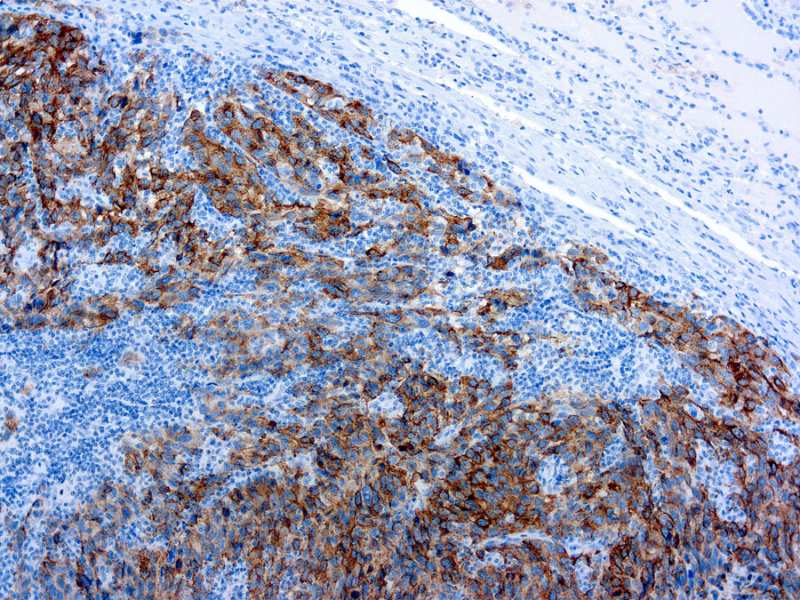

This antibody reacts with a neuraminidase sensitive oligosaccharide side chain of a glycoconjugate present in immature melanosomes. It reacts with junctional and blue nevus cells. Non-melanocytic cells are negative.
1ml
| Clone | HMB45 |
| Isotype | IgG1 |
| Application | IHC |
La documentación estará disponible en breve, mientras tanto, puede contactarnos por correo electrónico a specialist@histoline.com